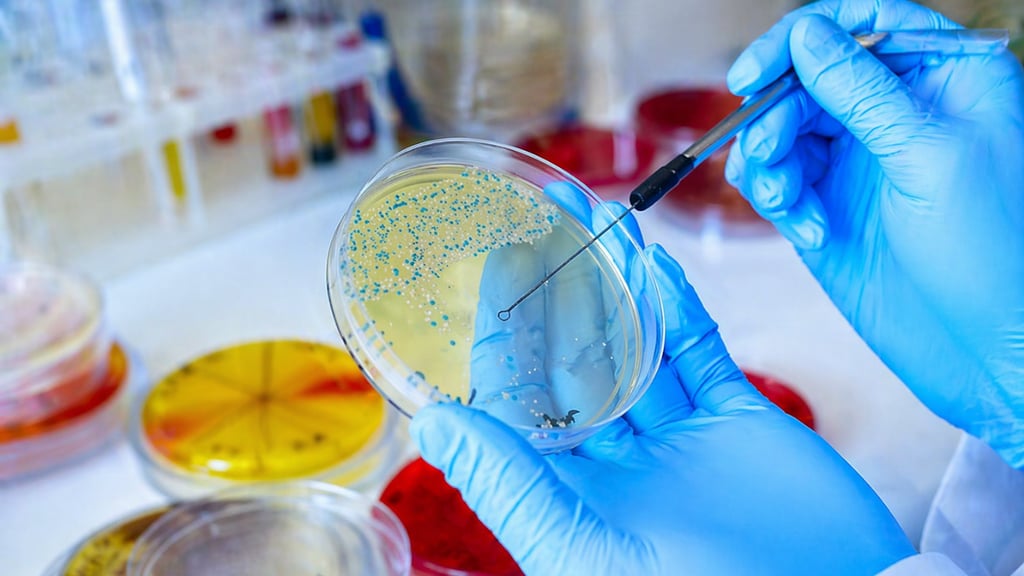

Superbactérias fora do hospital: fauna silvestre revela avanço silencioso da resistência antimicrobiana
Estudos apontam que animais selvagens podem atuar como sentinelas da disseminação de bactérias resistentes no ambiente, ampliando o alerta para a saúde pública global.
22/04/2026
2 min ler

A resistência antimicrobiana, frequentemente associada a ambientes hospitalares, está cada vez mais sendo detectada fora dessas estruturas. Um número crescente de pesquisas demonstra que a fauna silvestre pode desempenhar um papel importante como indicadora da circulação de chamadas “superbactérias” no meio ambiente.
Esses microrganismos resistentes a antibióticos, antes restritos a hospitais e clínicas, agora têm sido encontrados em ecossistemas naturais — incluindo florestas, rios e áreas urbanas periféricas. Esse cenário amplia significativamente o risco de disseminação e levanta preocupações importantes para a saúde pública.
🌿 O papel da fauna silvestre como sentinela ambiental
Animais selvagens, especialmente aves, roedores e mamíferos de pequeno porte, entram em contato direto com diferentes fontes de contaminação, como água poluída, resíduos urbanos e áreas impactadas por atividades humanas.
Esses animais podem carregar bactérias resistentes sem apresentar sinais clínicos, funcionando como verdadeiros “reservatórios móveis”. Esse fenômeno permite que a resistência antimicrobiana se espalhe entre diferentes ambientes — incluindo áreas consideradas preservadas.
Além disso, a mobilidade de algumas espécies, como aves migratórias, facilita ainda mais a dispersão dessas bactérias em longas distâncias.
🦠 Como surgem as superbactérias no ambiente?
A principal causa da resistência antimicrobiana continua sendo o uso inadequado de antibióticos em humanos, animais e na agricultura. Resíduos desses medicamentos podem contaminar o solo e a água, criando um ambiente propício para a seleção de bactérias resistentes.
Entre os fatores mais relevantes estão:
Uso indiscriminado de antibióticos na medicina humana;
Aplicação de antimicrobianos na pecuária;
Descarte inadequado de resíduos hospitalares e farmacêuticos;
Falta de tratamento adequado de esgoto.
Esse conjunto de fatores contribui para a chamada abordagem One Health, que reconhece a interconexão entre saúde humana, animal e ambiental.
⚠️ Impactos para a saúde pública
A presença de superbactérias fora do ambiente hospitalar aumenta o risco de infecções difíceis de tratar na comunidade. Isso significa que indivíduos sem histórico recente de internação também podem ser expostos a microrganismos resistentes.
Além disso, a circulação ambiental dessas bactérias dificulta o controle epidemiológico, tornando essencial a vigilância integrada entre setores da saúde, meio ambiente e pesquisa científica.
🔬 O que os estudos mais recentes mostram?
Pesquisas recentes identificaram genes de resistência antimicrobiana em amostras coletadas de animais silvestres em diferentes regiões do mundo. Esses achados indicam que a disseminação da resistência já ultrapassou barreiras geográficas e ecológicas.
Em alguns casos, foram detectadas bactérias com perfis de resistência semelhantes aos encontrados em ambientes hospitalares, sugerindo uma conexão direta entre atividades humanas e contaminação ambiental.
✅ Como reduzir esse problema?
A contenção da resistência antimicrobiana exige ações coordenadas:
Uso racional de antibióticos (prescrição adequada);
Investimento em saneamento básico;
Monitoramento ambiental contínuo;
Educação em saúde para profissionais e população;
Controle do uso de antimicrobianos na agropecuária.
👉 Quer entender como os exames laboratoriais ajudam a identificar bactérias resistentes e evitar erros críticos na prática clínica?
Acesse agora o Alerta Saúde e aprofunde seu conhecimento com conteúdos exclusivos para profissionais, estudantes e leigos. Informação de qualidade pode salvar vidas — inclusive a sua.
📚 Fontes
World Health Organization (WHO). Antimicrobial resistance.
Centers for Disease Control and Prevention (CDC). Antibiotic Resistance Threats Report.
Nature Reviews Microbiology. Studies on environmental dissemination of antimicrobial resistance.
The Lancet Microbe. Research on antimicrobial resistance and One Health.
Food and Agriculture Organization. Antimicrobial resistance and food systems.

